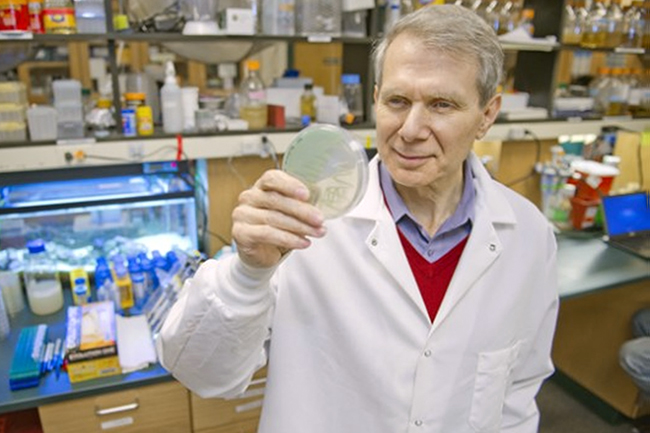

Амерички научници створили антибиотик на који бактерије не стичу отпорност
РУСКИ НАУЧНИК ВЛАИЉ КАЗНАЧЕЈЕВ УПОЗОРАВА ДА ДАНАШЊИ АНТИБИОТИЦИ ВОДЕ ЧОВЕЧАНСТВО ИЗУМИРАЊУ
Ким Луис
Ким Луис
- Ким Луис и његове колеге направили нови лек који делује и на бактеријске ћелије у „спавајућем режиму“ (перзисторе) на које не могу да утичу обични антибиотици
- Амерички научници истичу да антибиотик на бази ADEP4 може да избегне судбину свих својих претходника: како би научиле да му се супроставе, бактерије би морале да се одрекну протеазе ClpP без које нормалан живот њихових ћелија није могућ
ГРУПА америчких научника објавила је да је створила „принципијелно нови антибиотик, на који штетне бактерије неће моћи да се навикну“.
Учинила је то у чланку у реномираном часописа Nature.
Настанак код бактерија резистенције на антибиотике тера фармацеуте да стварају све нове и нове лекове. Међутим, микроорганизми мутирају веома брзо и зато међу њима настају деформације пред којима лекови постају немоћни. Зато неки лекари и научници већ упозоравају: ако човечанство престане да измишља нове антибактеријске лекове, постојећи антибиотици ће, једноставно, постати бескорисни.
Поменута група америчких научника, на челу са Кимом Луисом (Kim Lewis) са Северно-источног универзитета у Бостону, вероватно је успела да победи у овој „трци наоружања“. Јер, тврди да створила нови лек, на који бактерије практично не могу да се навикну! А осим тога: да тај лек делује и на бактеријске ћелије, које прелазе у „спавајући режим“.
Луис и његове колеге наглашавају да су ћелије бактерија недоступне обичним антибиотицима.
Јер, у свакој бактерији, укључујући и ћелије-перзисторе, постоји фермент протеаза ClpP способан да препозна и да подели неправилно денатурисане протеине. Протеазу активира супстанца ADEP-4 - а Луисова екипа управо ту супстанцу искористила као базичну. Прво су ADEP4 додали у колонију златних стафилокока, које су резистентне на многе антибиотике. Протеаза је покренула неконтролисану денатурацију протеина, што је довело до угинућа не само обичних ћелија, већ и перзистора.
Међутим ADEP4 није уништио колоније потпуно. У наредном експерименту, једињење је било појачано, додавањем стандардног антибиотика рифампицина. Добијени лек је био убризган мишу са тешком инфекцијом (изазваном великом дозом истих тих стафилокока). Кроз 24 сата инфекција је била излечена.
Амерички научници истичу да антибиотик на бази ADEP4 може да избегне судбину свих својих претходника: како би научиле да му се супроставе, бактерије би морале да се одрекну протеазе ClpP без које нормалан живот њихових ћелија није могућ.
Проблемом резистенције на антибиотике у читавом свету се баве најеминентније научне установе, међутим то уопште није једноставно. Играње „шуге“ са микробима - ти њима нови антибиотик, они теби кроз одређено време - резистенцију - скуп је спорт: развијање новог антибиотика данас кошта 800 млн. до 1 млрд. долара, и за то је, обично, потребно 8-10 година.
Притом, бактерије и гљиве мутирају чешће него људске ћелије, и зато оне довољно брзо уче да се штите од опасних супстанци. Осим тога, неке врсте бактерија „размењују искуство“ са рођацима, односно, буквално размењују генетски материјал и на тај начин стичу корисну, за њихову еволуцију, отпорност.
„Време антибиотика је прошло“
САВЕТНИК Центра за клиничку и експерименталну медицину Сибирског одељења Руске Медицинске Академије Влаиљ Казначејев упозорава: „Пеницилин је био револуција, он је одиграо историјску улогу, међутим, генерално, приступачност антибиотика и њихово „лако“ преписивање чак и деци, доводи нацију до ивице изумирања. Време антибиотика је прошло, постало је јасно да тај пут води у ћорсокак и сада је медицини потребно нешто принципијелно ново.
Превела Марија Петрова




















